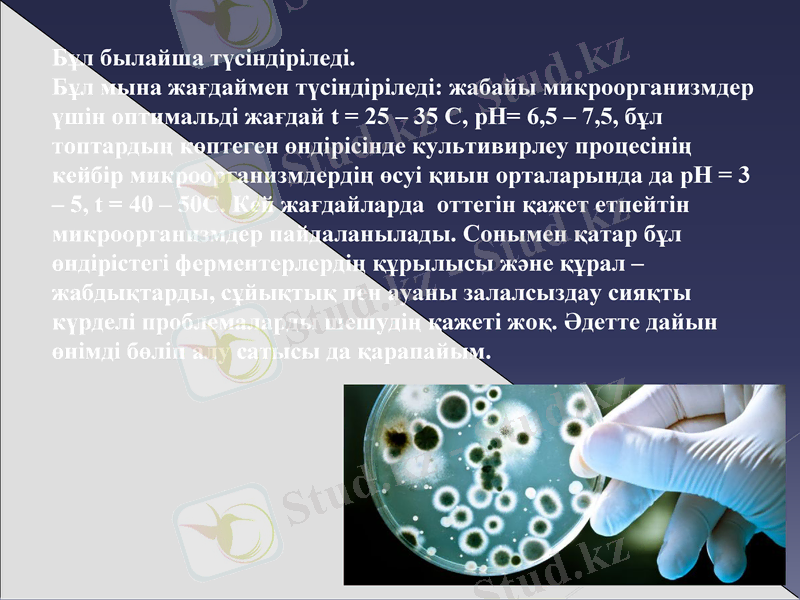
Slide 6
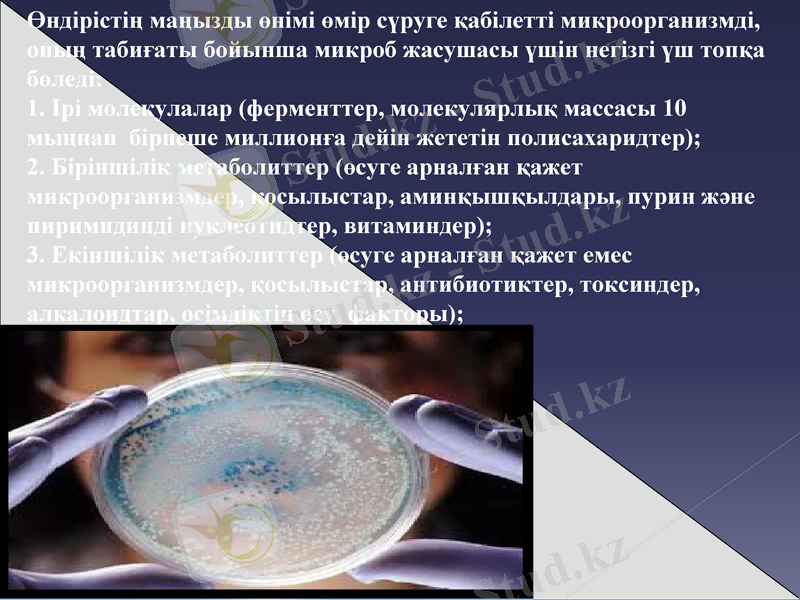
Slide 7

Микробтық массалар алу негізіндегі биотехнологиялық процестер



Микробтық массалар алуға негізделген биотехнологиялық процестер
Дайындаған: Орманбек А.
Топ: И-223-А
Тексерген: Ахметжанова А. М
ШЫҒЫС ҚАЗАҚСТАН ОБЛЫСЫ СЕМЕЙ ҚАЛАСЫ ҚАЗАҚ ИННОВАЦИЯЛЫҚ ГУМАНИТАРЛЫҚ-ЗАҢ УНИВЕРСИТЕТІ

Негізгі сұрақтар:
1. Биотехнологиялық жолмен алынатын өнімдерге көптеген препараттар және басқа да микробтық өнімдермен қамтамасыз ету;
2. Биотехнология биологиялық процестер мен объектілерді пайдалану
3. Микробтық массалар алуға негізделген биотехнологиялық процестерді практикада қолданумен танысу.

Биотехнология (bios - тіршілік; thechne-өнер, шеберлік; logos-ғылым) - адамның қатысуымен тірі ағзаларда биологиялық процестерді жүргізу барысында жаңа өнім алу; экономикалық құнды заттарды алу үшін ген және жасуша деңгейінде өзгертілген биологиялық объектілерді құрастыру технологиялары мен пайдалану жөніндегі ғылым және өндіріс саласы.


Биотехнологиялық процесті қолданатын өндіріс салаларын екі топқа бөлуге :
- Ашыту өндірісі, тамақ өндірісі, ауылшаруашылық шикізатын өңдеумен айналысады. Мұнда технологиялық процестің қандай да бір сатысында микроорганизмді қолдану шектелген. Осы саладағы микроорганизмдер үшін арнайы технологиялық жабдықтардың азырақ көлемі бар. Берілген топтағы өндіріс жеке тамақ өндірісі құрамына кіреді.
- Өндірістің негізгі сатысы бұл микроорганизмдерді культивирлеу. Технологиялық белгілері бойынша оларды екі топқа бөлуге болады:
- Микроорганизмдердің көп мөлшерде биомассасын алумен байланысты көптонналы өндіріс. Осы өндірістің негізгі технологиялық құрал - жабдық түрін анықтайтын сипаттамасы - түптік культивирлеу. Бұл жерде бөгде микрофлораның түсу мүмкіншілігі өте аз болғандықтан, жоғары дәрежелі асептиканы қажет етпейді
Бұл былайша түсіндіріледі.
Бұл мына жағдаймен түсіндіріледі: жабайы микроорганизмдер үшін оптимальді жағдай t = 25 - 35 С, рН= 6, 5 - 7, 5, бұл топтардың көптеген өндірісінде культивирлеу процесінің кейбір микроорганизмдердің өсуі қиын орталарында да рН = 3 - 5, t = 40 - 50С. Кей жағдайларда оттегін қажет етпейтін микроорганизмдер пайдаланылады. Сонымен қатар бұл өндірістегі ферментерлердің құрылысы және құрал - жабдықтарды, сұйықтық пен ауаны залалсыздау сияқты күрделі проблемаларды шешудің қажеті жоқ. Әдетте дайын өнімді бөліп алу сатысы да қарапайым.
Өндірістің маңызды өнімі өмір сүруге қабілетті микроорганизмді, оның табиғаты бойынша микроб жасушасы үшін негізгі үш топқа бөледі:
1. Ірі молекулалар (ферменттер, молекулярлық массасы 10 мыңнан бірнеше миллионға дейін жететін полисахаридтер) ;
2. Біріншілік метаболиттер (өсуге арналған қажет
микроорганизмдер, қосылыстар, аминқышқылдары, пурин және пиримидинді нуклеотидтер, витаминдер) ;
3. Екіншілік метаболиттер (өсуге арналған қажет емес микроорганизмдер, қосылыстар, антибиотиктер, токсиндер, алкалоидтар, өсімдіктің өсу факторы) ;

Микробты синтез өнімдері өндірістік кәсіпорынның рентабельды аумағы болу үшін қоректік ортада микробтық клетка түрінде бөлінуі керек және микроорганизмдердің культивирленуіне қажет шикізат және энергетикалық шығыны ақталатын мөлшерде қоректік ортада жиналуы керек, сонымен қатар әрмен қарай қолдануға арналған қажетті өнімді бөліп алады. Көптеген жағдайларда сол немесе басқа өнімді микробиологиялық әдіспен алуды таңдау барысында басқа әдіспен алу шектелген, ең біріншісі - химиялық синтездеу жолымен алу. Көптеген антибиотиктер, ферменттер, биологиялық активтік заттар, пуриндік нуклеотидтер, токсиндер, өсімдіктердің өсу факторларын қазіргі уақытта көп сатылы химиялық синтез немесе 1-2 сатылы ферментативті синтез және күрделі және табылуы қиын шикізаттарға негізделген күрделі процестерге қарағанда, микроорганизмдерді алуда оңай табылатын және арзан штикізаттан алған жөн.

БІРАҚТА ТАЛАПҚА СӘЙКЕС МИКРООРГАНИЗМДЕРДІҢ ТАБИҒИ ШТАМДАРЫ, ҚОРЕКТІК ОРТАДА БӨЛІНУГЕ ЖӘНЕ ЖИНАЛУҒА ҚАБІЛЕТСІЗ, ЯҒНИ ОНЫҢ БАҒАСЫ ТӨМЕН ЖӘНЕ ХАЛЫҚ ШАРУАШЫЛЫҒЫ МЕН МЕДИЦИНАҒА ҚАЖЕТ ӨНДІРІС КӨЛЕМІН ҚАМТАМАСЫЗ ЕТЕ АЛАТЫН ҚАЖЕТТІ ӨНІМ МӨЛШЕРІН ПРОДУЦИРЛЕЙ АЛМАЙДЫ. КЕЙБІР МИКРООРГАНИЗМДЕР ТОПТАРЫНЫҢ ТАБИҒИ ШТАМДАРЫ (ЖЕТІЛМЕГЕН САҢЫРАУҚҰЛАҚТАР, АКТИНОМИЦЕТТЕР, БАЦИЛЛАЛАР) ҚОРШАҒАН ОРТАҒА АНТИБИОТИКТЕРДІҢ ТОКСИНДЕРДІҢ НЕМЕСЕ ГИДРОЛИТИКАЛЫҚ ФЕРМЕНТТЕРДІҢ АЗЫРАҚ МӨЛШЕРІН БӨЛУГЕ ҚАБІЛЕТТІ.

Биологиялық активтік заттың продуцентін селекциялау әдісі бүгінде гендік инженерия әдісінің қарқынды дамуы дәстүрлі болып табылады. Бұл әдістер өткен 50 жылдары көлемді болып микробиологиялық өндірісте антибиотик, амин қышқылы, фермент, витаминге және басқада іс жүзінде маңызды заттарға әсер етеді.

- Іс жүргізу
- Автоматтандыру, Техника
- Алғашқы әскери дайындық
- Астрономия
- Ауыл шаруашылығы
- Банк ісі
- Бизнесті бағалау
- Биология
- Бухгалтерлік іс
- Валеология
- Ветеринария
- География
- Геология, Геофизика, Геодезия
- Дін
- Ет, сүт, шарап өнімдері
- Жалпы тарих
- Жер кадастрі, Жылжымайтын мүлік
- Журналистика
- Информатика
- Кеден ісі
- Маркетинг
- Математика, Геометрия
- Медицина
- Мемлекеттік басқару
- Менеджмент
- Мұнай, Газ
- Мұрағат ісі
- Мәдениеттану
- ОБЖ (Основы безопасности жизнедеятельности)
- Педагогика
- Полиграфия
- Психология
- Салық
- Саясаттану
- Сақтандыру
- Сертификаттау, стандарттау
- Социология, Демография
- Спорт
- Статистика
- Тілтану, Филология
- Тарихи тұлғалар
- Тау-кен ісі
- Транспорт
- Туризм
- Физика
- Философия
- Халықаралық қатынастар
- Химия
- Экология, Қоршаған ортаны қорғау
- Экономика
- Экономикалық география
- Электротехника
- Қазақстан тарихы
- Қаржы
- Құрылыс
- Құқық, Криминалистика
- Әдебиет
- Өнер, музыка
- Өнеркәсіп, Өндіріс
Қазақ тілінде жазылған рефераттар, курстық жұмыстар, дипломдық жұмыстар бойынша біздің қор #1 болып табылады.



Ақпарат
Қосымша
Email: info@stud.kz